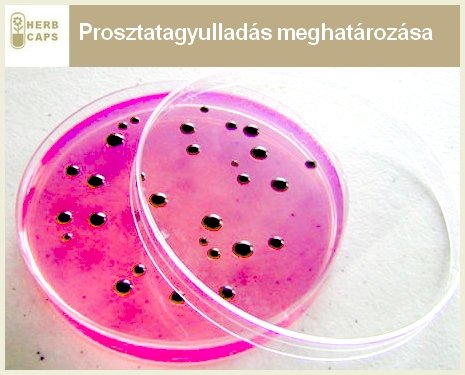

|
|
A prosztatagyulladás felismerhető tünetei
A tünetek az esetek nagy számában bizonytalan jellegűek, pontos helyük nehezen, vagy alig meghatározható. Viszont, ami szinte minden pácienst érint, így a prosztatagyulladás leggyakoribb tünete a gyakori vizelési inger, mely vizeletürítéskor erős fájdalommal társul. A betegek gyakran számolnak be deréktáji, alhasi, gáttáji, heretáji, comb belső táji fájdalomról. A betegek egy része az orvoshoz való fordulásukkor még megemlíti a farizom és csípőtájéki fájdalmat. A gyulladás az esetek többségében lázzal jár. A vizelet lehet véres, az általános állapotot a levertség jellemzi. Súlyosabb esetekben genny alakulhat ki a prosztatában, krónikus esetben akár nemzőképtelenséget is okozhat. A nemi érintkezés közben az ejakuláció erős fájdalommal jár. A gát tájékán enyhe nyomás esetén gyengébb, erősebb nyomás esetén nagyobb fájdalmat érzünk. A legtöbb esetben hirtelen jelentkezik, gyorsan fellángol és gyors lefolyású. Érdemes minden esetben odafigyelni rá, mert komoly problémát okozhat a későbbiekben.
A prosztatitisz oka, eredete
A proszttitisz okai pontosan még nem tisztázottak. Azonban a jelenlegi tudományos álláspont szerint az alábbi okokat, okozókat jelöli meg fő bűnösként.
Bakteriális fertőzés: A prosztatitisz hátterében Enterobacterica és Enterococcusok baktériumok állnak. Ezek a baktériumok a bélflóránk része, melyek a vastagbélben élnek. A leggyakoribb baktérium, melyet kimutattak az aEscherichia coli baktérium, amit mindenki ismer. Azt valószínűsítik, hogy a prosztata nem megfelelő működése révén nem megfelelő váladékot termel, aminek következtében a kórokozók könnyen elszaporodhatnak.
Vizelet bejutása a prosztatába: Bizonyos feltételezések szerint a gyulladást a vizelet visszaáramlása okozza, melyben lévő baktériumok, bizonyos kémiai anyagok megbetegítik a prosztatát. Sok olyan kémiai anyagot sikerült meghatározni, amely a prosztatagyulladásért felelős.
A stressz, mint jelentős tényező : Egyes szakértők úgy vélik, hogy a prosztatagyulladás pszichoszomatikus betegség.Ami biztosra vehető, hogy a lelki állapot biztosan befolyásolja a gyulladás kialakulását és a gyulladás gyors lefolyásának mértékét.
A prostatitis betegség megállapítása, kezelése
Módszerek a prosztatagyulladás kezelésében
A legtöbb esetben a bakteriális fertőzésekből eredő gyulladásra antibiotikumot írnak fel az orvosok. Ez a leggyakoribb eset. Akkut gyulladás esetén a kezelés időtartama akár 4 hétig is eltarthat. A krónikus gyulladásnál a bevált módszer az alfa-receptor-blokkolók használata, mely segít a simaizomsejtek ellazulásában, ezáltal kialakítva a megfelelő vizeletáramlást. Az alternatív gyógyászat is ezekre a tapasztalatokra épít, mikor izomlazító gyakorlatok segítségével javítja a prosztata működését. Napjainkban elterjed intim torna is hasznos lehet a medence izomzatának karbantartására az intim szervek karbantartásának érdekében. Étkezés során mindenféleképpen kerülendő az alkohol és a savasító ételek. Új módszerként jelent meg a prosztata hőterápia, mely klinikai vizsgálatokkal még nem alátámasztott, de a kezelés ígéretesnek tűnik.
————————————
..


Kommentek